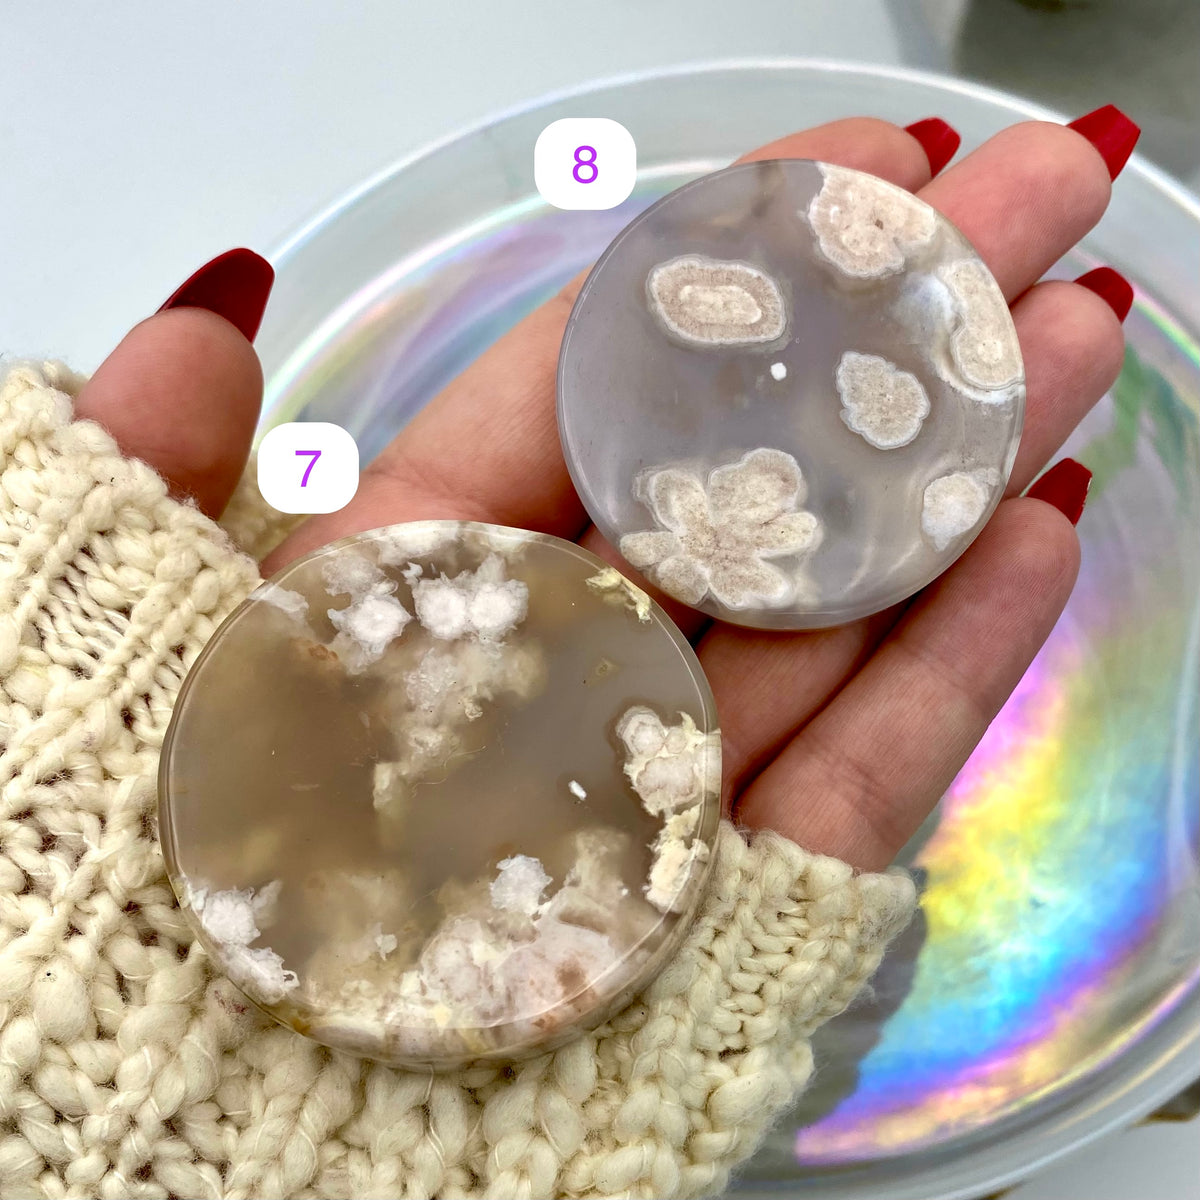
Flower Agate Discs / Rounds

Your Cart is Empty







Flower Agate Discs / Rounds
$11.11$14.44
Healing ~ Motivation ~ Self Growth 💕
All crystals are intuitively chosen unless otherwise stated.
Crystals are from the Earth & may have imperfections such as natural cracks & inclusions.
Listing includes -one- crystal.
Please see images for sizing purposes.